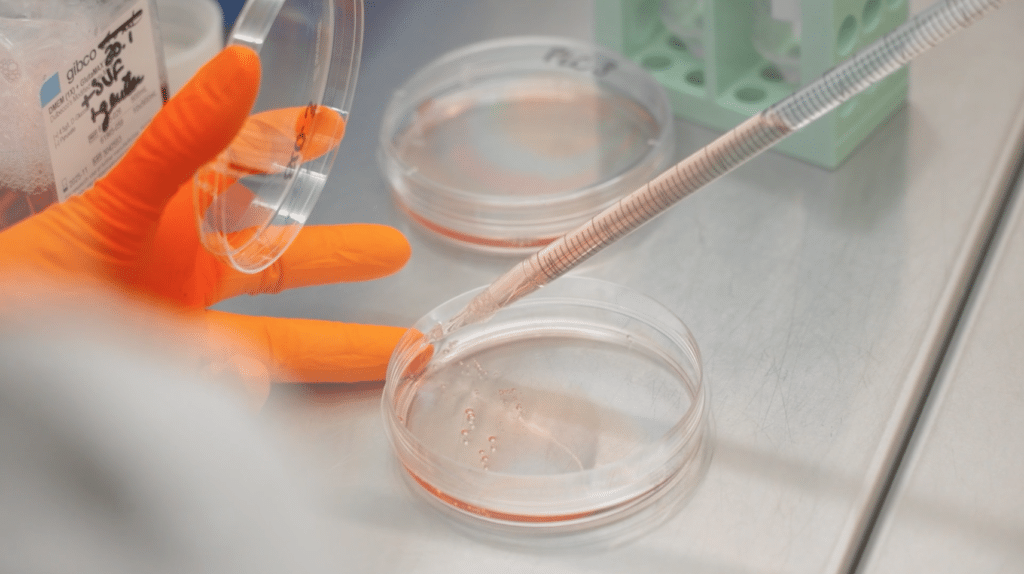

Envie d’accompagner au quotidien le bon fonctionnement de nos activités de soutien? La Fondation Leenaards recherche son-sa futur-e gestionnaire administratif-ve / assistante-e de projet (à 100% – poste en présentiel) pour accompagner le développement de ses actions. Consultez l’annonce complète et les modalités de candidature.
Délai de postulation : lundi 25 juillet.